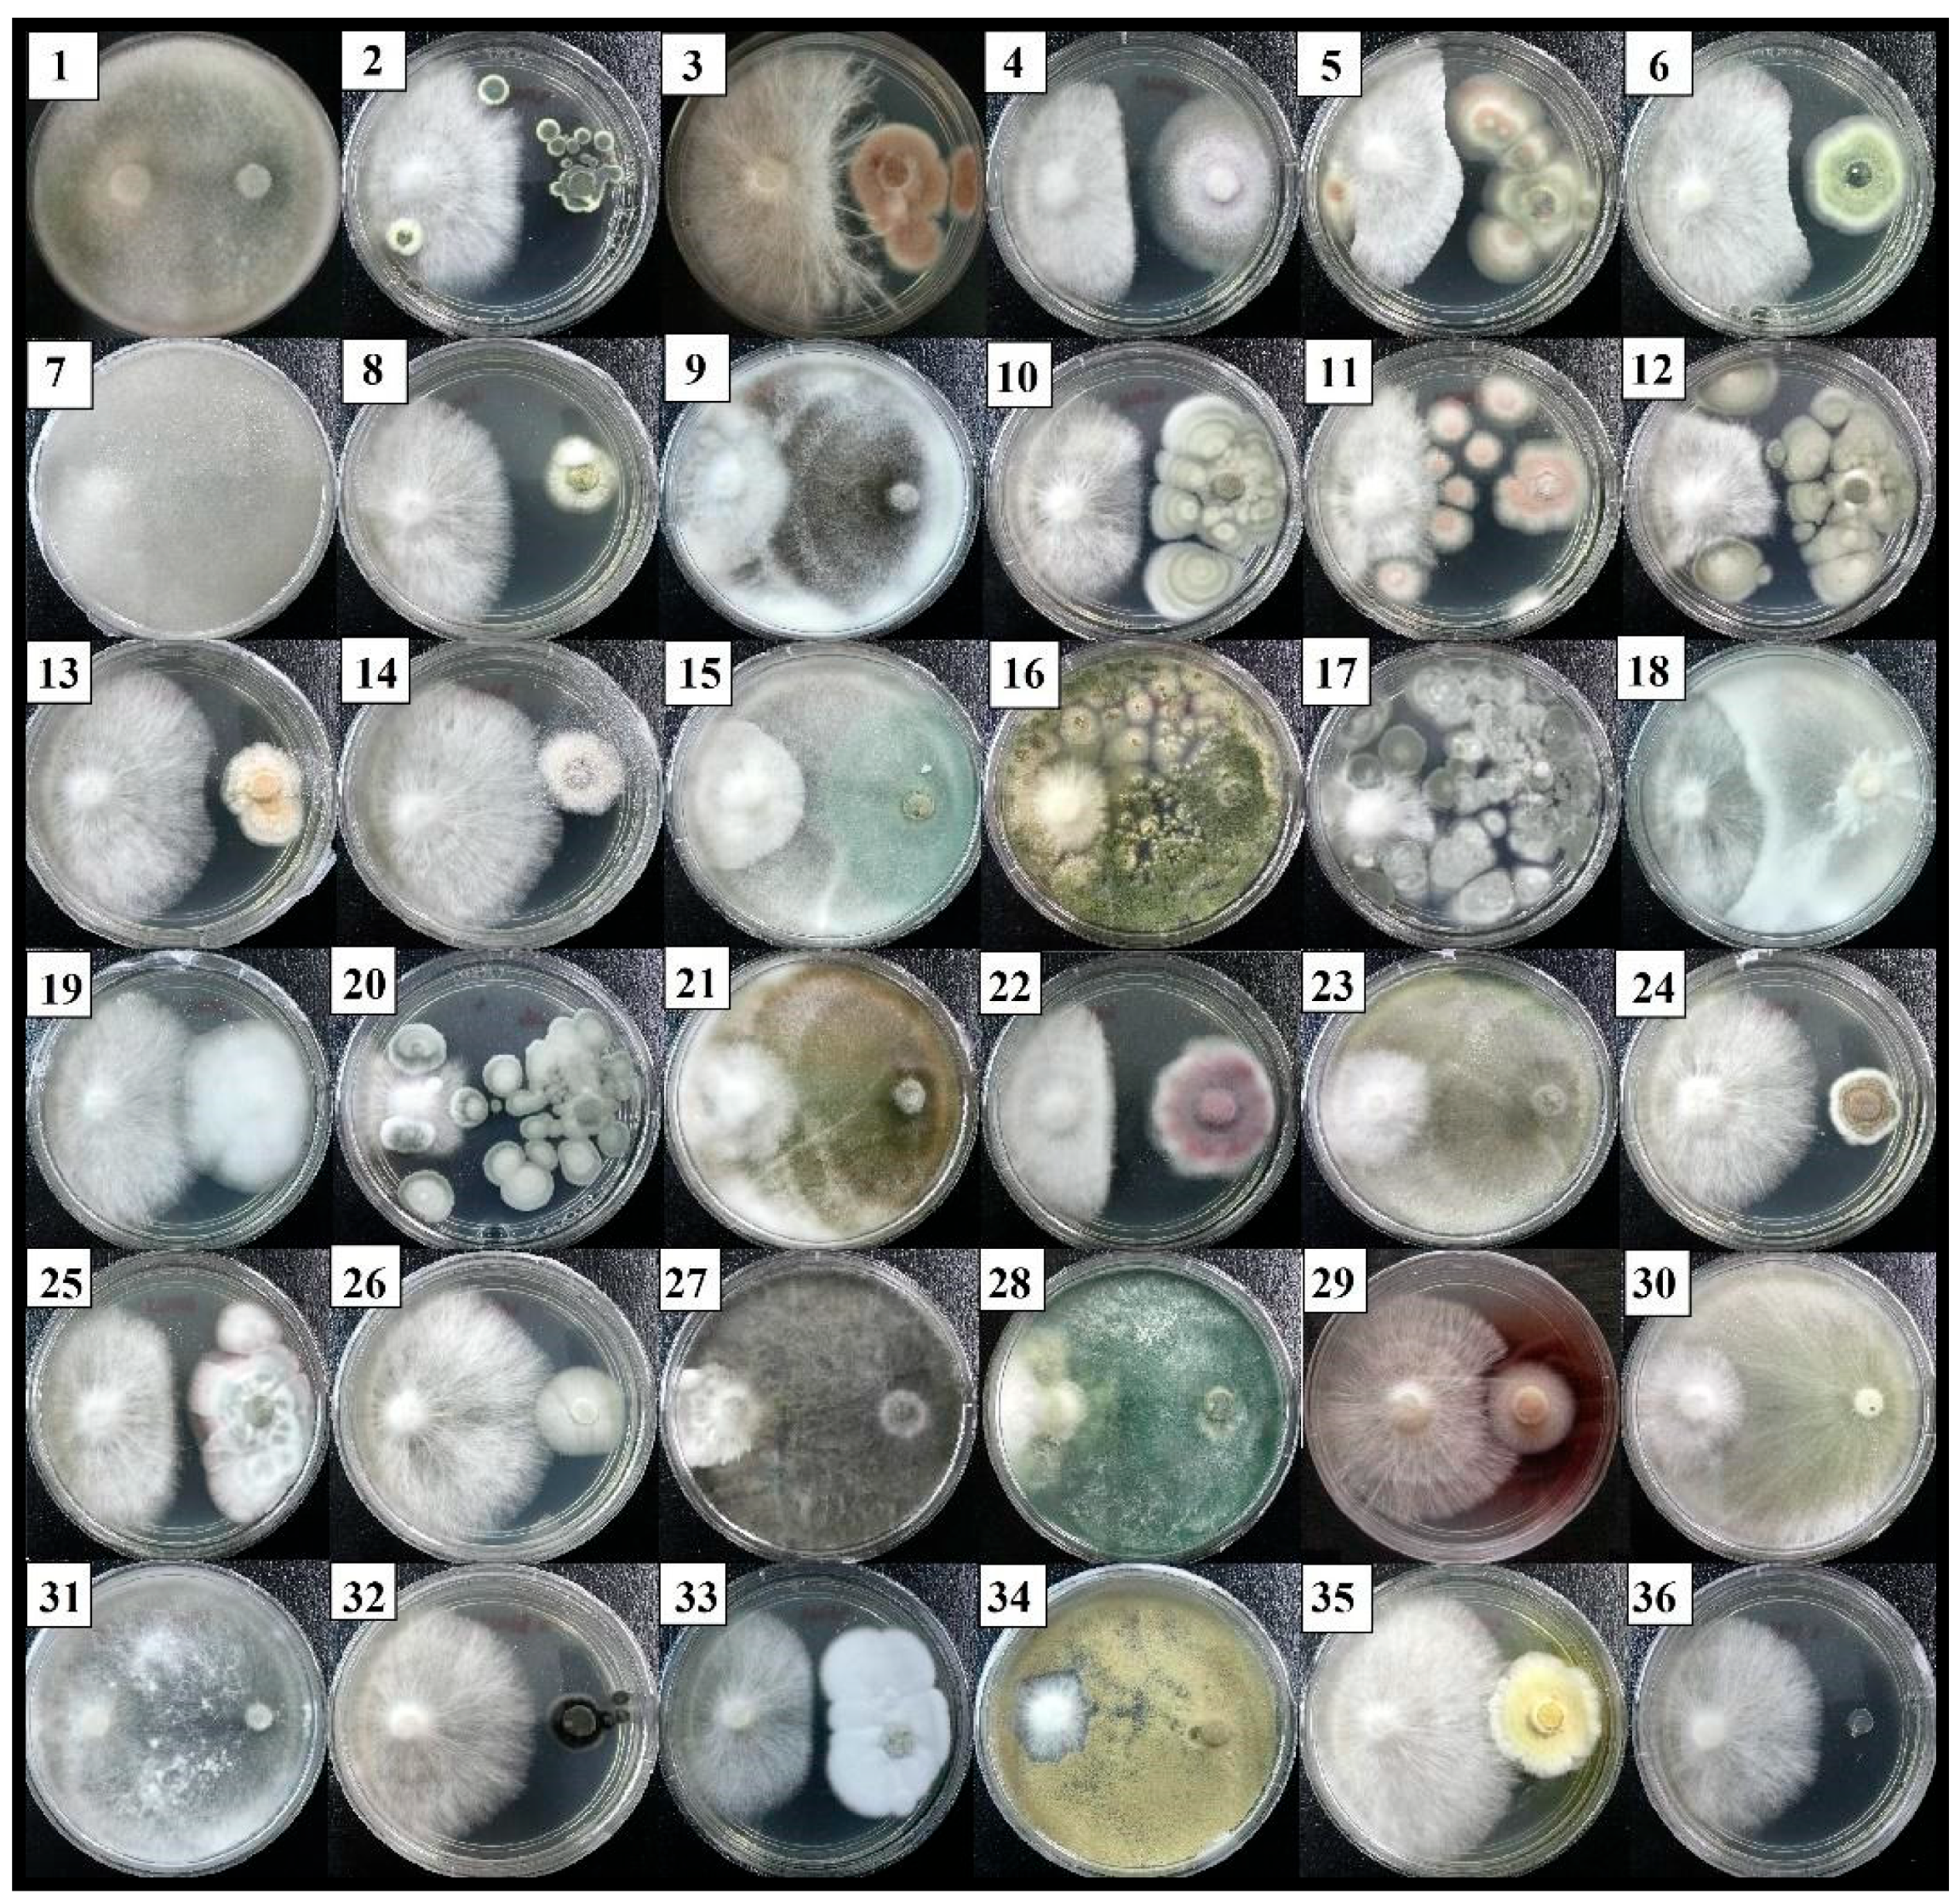
Plants 12 01066 g001

Exploring the Biocontrol Efficacy of Trichoderma spp. against Rigidoporus microporus, the Causal Agent of White Root Rot Disease in Rubber Trees (Hevea brasiliensis)
Abstract
1. Introduction
2. Materials and Methods
2.1. Pathogen and Potential Antagonists
2.2. In Vitro Dual Culture Bioassays
- r1 = the colony radius of the pathogen in control and
- r2 = the colony radius of the pathogen in treatment.
- R1 = 100% overgrowth;
- R2 = 75% overgrowth;
- R3 = 50% overgrowth;
- R4 = growth inhibition at the line of contact; and
- R5 = the pathogen over the growing antagonist.
2.3. Characterization of Trichoderma Isolates
2.3.1. Antifungal Activities
Non-Volatile Compounds
Volatile Compound
Identification of Antifungal Metabolites
2.3.2. Production of Extracellular Hydrolytic Enzymes
Chitinase
Cellulase
β-1,3-glucanase
2.3.3. Plant Growth Promotion Activity
Indole Acetic Acid Production
Phosphate Solubilization Test
Siderophores Production
2.3.4. Biochemical Properties Index
2.4. Nursery Experiments
2.4.1. Biocontrol and Pathogen Inoculum Preparation
2.4.2. Rubber Seedlings Inoculation
2.4.3. Disease Severity Assessment
- S0, S1, and S2, …, SH are the disease severity scores (0 to 4 for above-ground symptoms and 0 to 5 for below-ground symptoms),
- XS1, XS2, and XS3, …, XSH are number of plants that are classified under the specific disease severity scoring,
- Xsum is the total of plants, and
- SH is the the highest scoring of disease severity classification: 4 for above-ground symptoms or 5 for below-ground symptoms.
- s1 = Disease severity index in the positive control and
- s2 = Disease severity index in the biocontrol or chemical treatment.
2.4.4. Transmission Electron Microscopy (TEM) Observation
2.5. Statistical Analysis
3. Results and Discussion
3.1. Identification and Selection of Potential Antagonistic Fungi through Dual Culture Assays
3.2. Characterization of Antifungal Activity of selected Trichoderma Isolates
3.2.1. Non-Volatile Compounds
3.2.2. Volatile Compounds
3.2.3. Production of Extracellular Hydrolytic Enzymes
3.2.4. Plant Growth Promotion Activity
3.2.5. Scoring of the Biochemical Properties Index
3.3. Nursery Experiments
3.3.1. Disease assessment
3.3.2. Transmission Electron Microscopy (TEM) Observation
4. Conclusions
Author Contributions
Funding
Institutional Review Board Statement
Informed Consent Statement
Data Availability Statement
Acknowledgments
Conflicts of Interest
References
- Omorusi, V.I. Effects of white root rot disease on Hevea brasiliensis (Muell. Arg.)—Challenges and control approach. In Plant Science; Kumarand, D.N., Sahu, S.C., Eds.; Intech: London, UK, 2012; pp. 139–152. [Google Scholar]
- Ogbebor, N.O.; Adekunle, A.T.; Eghafona, N.O.; Ogboghodo, A.I. Ganoderma psuedoferreum: Biological control possibilities with microorganisms isolated from soils of rubber plantations in Nigeria. Afr. J. Gen. Agric. 2010, 6, 301–305. [Google Scholar]
- Chaiharn, M.; Sujada, N.; Pathom-Aree, W.; Lumyong, S. Biological control of Rigidoporus microporus the cause of white root disease in rubber using PGPRs in vivo. Chiang Mai J. Sci. 2019, 46, 850–866. [Google Scholar]
- Ogbebor, N.O.; Adekunle, A.T.; Eghafona, O.N.; Ogboghodo, A.I. Biological control of Rigidoporus lignosus in Hevea brasiliensis in Nigeria. Fungal Biol. 2015, 119, 1–6. [Google Scholar] [CrossRef] [PubMed]
- Kaewchai, S.; Soytong, K. Application of biofungicides against Rigidoporus microporus causing white root disease of rubber trees. J. Agric. Technol. 2010, 6, 349–363. [Google Scholar]
- Nakaew, N.; Rangjaroen, C.; Sungthong, R. Utilization of rhizospheric Streptomyces for biological control of Rigidoporus sp. causing white root disease in rubber tree. Eur. J. Plant Pathol. 2015, 142, 93–105. [Google Scholar] [CrossRef]
- Wattanasilako, S.; Wattanasilakorn, S.; Sdoodee, S.; Nualsri, C.; Chuenchit, S. Screening of rubber (Hevea brasiliensis Muell. Arg.) rootstocks for the white root disease resistance. Int. J. Agric. Technol. 2012, 8, 2385–2395. [Google Scholar]
- Prasetyo, J.; Aeny, T.N.; Suharjo, R. The corelations between white rot (Rigidoporus Lignosus L.) incidence and soil characters of rubber ecosystem in Penumangan Baru, Lampung. J. Hama dan Penyakit Tumbuh. Trop. 2009, 9, 149–157. [Google Scholar] [CrossRef]
- Jayaratne, R.; Wettasinghe, P.C.; Siriwardene, D.; Peiris, P. Systemic fungicides as a drench application to control white root disease of rubber. J. Rubber Res. Inst. Sri Lanka 2001, 84, 1–17. [Google Scholar]
- Ng, K.J.; Yap, T.H. The effects of triadimefon and triadimenol in controlling white root disease of rubber. In Proceedings of the 3rd International Conference of Plant Protection in the Tropics, Genting Highlands, Pahang, Malaysia, 20–23 March 1990; Volume 2, pp. 31–35. [Google Scholar]
- Syed Ab Rahman, S.F.; Singh, E.; Pieterse, C.M.J.; Schenk, P.M. Emerging microbial biocontrol strategies for plant pathogens. Plant Sci. 2018, 267, 102–111. [Google Scholar] [CrossRef]
- Mavrodi, D.V.; Yang, M.; Mavrodi, O.V.; Wen, S. Management of soilborne plant pathogens with beneficial root-colonizing Pseudomonas. Adv. PGPR Res 2017, 147, 147–164. [Google Scholar]
- Riseh, R.S.; Skorik, Y.A.; Thakur, V.K.; Pour, M.M.; Tamanadar, E.; Noghabi, S.S. Encapsulation of plant biocontrol bacteria with alginate as a main polymer material. Int. J. Mol. Sci. 2021, 22, 11165. [Google Scholar] [CrossRef] [PubMed]
- Naseri, B.; Younesi, H. Beneficial microbes in biocontrol of root rots in bean crops: A meta-analysis (1990–2020). Physiol. Mol. Plant Pathol. 2021, 116, 101712. [Google Scholar] [CrossRef]
- Xue, M.; Wang, R.; Zhang, C.; Wang, W.; Zhang, F.; Chen, D.; Ren, S.; Manman, Z.; Hou, J.; Liu, T. Screening and identification of Trichoderma Strains isolated from natural habitats in china with potential agricultural applications. BioMed Res. Int. 2021, 2021, 7913950. [Google Scholar] [CrossRef] [PubMed]
- Upadhyay, M.; Awasthi, A. Exploring biocontrol efficacy of Trichoderma spp. against Fusarium sacchari, the causal agent of sugarcane wilt. Biotecnol. Veg. 2020, 20, 237–247. [Google Scholar]
- Palmieri, D.; Ianiri, G.; Del Grosso, C.; Barone, G.; De Curtis, F.; Castoria, R.; Lima, G. Advances and perspectives in the use of biocontrol agents against fungal plant diseases. Horticulturae 2022, 8, 577. [Google Scholar] [CrossRef]
- Thambugala, K.M.; Daranagama, D.A.; Phillips, A.J.L.; Kannangara, S.D.; Promputtha, I. Fungi vs. fungi in biocontrol: An Overview of fungal antagonists applied against fungal plant pathogens. Front. Cell. Infect. Microbiol. 2020, 10, 604923. [Google Scholar] [CrossRef]
- Sakpetch, P.; H-Kittikun, A.; Kuwahara, Y.; Komeda, H.; Asano, Y. Isolation of indigenous antagonistic microorganism to inhibit Rigidoporus microporus and other plant pathogens and analysis of the bioactive compounds. Biol. Control 2018, 124, 53–60. [Google Scholar] [CrossRef]
- Herath, H.H.M.A.U.; Wijesundera, R.L.C.; Chandrasekharan, N.V.; Wijesundera, W.S.S. Exploration of Sri Lankan soil fungi for biocontrol properties. Afr. J. Biotechnol. 2017, 16, 1168–1175. [Google Scholar] [CrossRef]
- Suryanto, D.; Munthe, R.A.; Nurwahyuni, I.; Munir, E. An assay on potential of local trichoderma spp. to control white root rot disease caused by Rigidoporus microporus in rubber plant stump. J. Pure Appl. Microbiol. 2017, 11, 717–723. [Google Scholar] [CrossRef]
- Rahman, S.S.M.S.A.; Zainudin, N.A.I.M.; Aziz, N.A.A. Evaluation of Trichoderma asperellum B1902 in controlling Fusarium Wilt of cavendish banana cultivar. Sains Malays. 2021, 50, 2549–2561. [Google Scholar] [CrossRef]
- Nusaibah, S.A.; Musa, H. A Review report on the mechanism of Trichoderma spp. as biological control agent of the basal stem rot (BSR) disease of elaeis guineensis. In Trichoderma—The Most Widely Used Fungicide Carrier; Shah, M.M., Sharif, U., Buhari, T.R., Eds.; IntechOpen: London, UK, 2019; pp. 1–12. ISBN 978-1-78923-918-8. [Google Scholar]
- Ali, A.; Zeshan, M.A.; Mehtab, M.; Khursheed, S.; Mudasir, M. A comprehensive note on trichoderma as a potential biocontrol agent against soil borne fungal pathogens: A review. Plant Prot. 2021, 5, 171–196. [Google Scholar] [CrossRef]
- Amaria, W.; Harni, R.; Samsudin, S. Evaluasi jamur antagonis dalam menghambat pertumbuhan Rigidoporus microporus penyebab penyakit jamur akar putih pada tanaman karet. J. Tanam. Ind. Dan Penyegar 2015, 2, 51–60. [Google Scholar] [CrossRef]
- Jayasuriya, K.E.; Thennakoon, B.I. Biological control of Rigidoporus microporus, the cause of white root disease in rubber. Ceylon J. Sci. Biol. Sci. 2007, 36, 9–16. [Google Scholar]
- Harman, G.E.; Howell, C.R.; Viterbo, A.; Chet, I.; Lorito, M. Trichoderma species—Opportunistic, avirulent plant symbionts. Nat. Rev. Microbiol. 2004, 2, 43–56. [Google Scholar] [CrossRef] [PubMed]
- Benítez, T.; Rincón, A.M.; Limón, M.C.; Codón, A.C. Biocontrol mechanisms of Trichoderma strains. Int. Microbiol. 2004, 7, 249–260. [Google Scholar] [PubMed]
- Go, W.Z.; Chin, K.L.; H’ng, P.S.; Wong, M.Y.; Luqman, C.A.; Surendran, A.; Tan, G.H.; Lee, C.L.; Khoo, P.S.; Kong, W.J. Virulence of Rigidoporus microporus isolates causing white root rot disease on rubber trees (Hevea brasiliensis) in Malaysia. Plants 2021, 10, 2123. [Google Scholar] [CrossRef] [PubMed]
- Go, W.Z.; H’Ng, P.S.; Wong, M.Y.; Tan, G.H.; Luqman Chuah, A.; Salmiah, U.; Toczyłowska-Mamińska, R.; Soni, O.; Wong, W.Z.; Chin, K.L.; et al. Occurrence and characterisation of mycoflora in soil of different health conditions associated with white root rot disease in Malaysian rubber plantation. J. Rubber Res. 2015, 18, 159–170. [Google Scholar]
- Lin, Y.H.; Chang, J.Y.; Liu, E.T.; Chao, C.P.; Huang, J.W.; Chang, P.F.L. Development of a molecular marker for specific detection of Fusarium oxysporum f. sp. cubense race 4. Eur. J. Plant Pathol. 2009, 123, 353–365. [Google Scholar] [CrossRef]
- White, T.J.; Bruns, T.; Lee, S.; Taylor, J. Amplification and direct sequencing of fungal ribosomal RNA genes for phylogenetics. In PCR Protocols: A Guide to Methods and Applications; Innis, M.A., Gelfand, D.H., Sninsky, J.S., Eds.; Academic Press: New York, NY, USA, 1990; pp. 315–322. [Google Scholar]
- Fokkema, N.J. Fungal antagonisms in the phyllosphere. Ann. Appl. Biol. 1978, 89, 115–119. [Google Scholar] [CrossRef]
- Korsten, L.; De Jager, E.S.; De Villiers, E.E.; Lourens, A.; Kotze, J.M.; Wehner, F.C. Evaluation of bacterial epiphytes isolated from avocado leaf and fruit surfaces for biocontrol of avocado postharvest diseases. Plant Dis. 1995, 79, 1149–1156. [Google Scholar] [CrossRef]
- Dennis, C.; Webster, J. Antagonistic properties of species-groups of Trichoderma. Trans. Br. Mycol. Soc. 1971, 57, 25-IN3. [Google Scholar] [CrossRef]
- Bendahmane, B.S.; Mahiout, D.; Benzohra, I.E.; Benkada, M.Y. Antagonism of three Trichoderma species against Botrytis fabae and B. cinerea, the causal agents of chocolate spot of faba bean (Vicia faba L.) in Algeria. World Appl. Sci. J. 2012, 17, 278–283. [Google Scholar]
- Siddiquee, S.; Cheong, B.E.; Taslima, K.; Kausar, H.; Hasan, M.M. Separation and identification of volatile compounds from liquid cultures of Trichoderma harzianum by GC-MS using three different capillary columns. J. Chromatogr. Sci. 2012, 50, 358–367. [Google Scholar] [CrossRef] [PubMed]
- Murthy, N.; Bleakley, B. Simplified method of preparing colloidal chitin used for screening of chitinase- producing microorganisms. Internet J. Microbiol. 2012, 10, e2bc3. [Google Scholar] [CrossRef]
- Téllez-Téllez, M.; Fernández, F.J.; Montiel-González, A.M.; Sánchez, C.; Díaz-Godínez, G. Growth and laccase production by Pleurotus ostreatus in submerged and solid-state fermentation. Appl. Microbiol. Biotechnol. 2008, 81, 675–679. [Google Scholar] [CrossRef]
- Zehra, A.; Dubey, M.K.; Meena, M.; Upadhyay, R.S. Effect of different environmental conditions on growth and sporulation of some Trichoderma species. J. Environ. Biol. 2017, 38, 197–203. [Google Scholar] [CrossRef]
- Sharifi Noori, M.S.; Mohd Saud, H. Potential plant growth-promoting activity of Pseudomonas sp isolated from paddy soil in Malaysia as biocontrol agent. J. Plant Pathol. Microbiol. 2012, 03, 2–5. [Google Scholar] [CrossRef]
- Cherkupally, R.; Amballa, H.; Bhoomi, N.R. In vitro screening for enzymatic activity of Trichoderma species for biocontrol potential. Ann. Plant Sci. 2017, 6, 1784. [Google Scholar] [CrossRef]
- Wattanasilakorn, S.; Sdoodee, S.; Nualsri, C.; Bunratchoo, S. Screening of rubber rootstock by the assessment of root growth and genetic background. Kasetsart J.-Nat. Sci. 2015, 49, 821–831. [Google Scholar]
- Gafni, A.; Calderon, C.E.; Harris, R.; Buxdorf, K.; Dafa-Berger, A.; Zeilinger-Reichert, E.; Levy, M. Biological control of the cucurbit powdery mildew pathogen Podosphaera xanthii by means of the epiphytic fungus Pseudozyma aphidis and parasitism as a mode of action. Front. Plant Sci. 2015, 6, 132. [Google Scholar] [CrossRef]
- Yu, J.; Walther, G.; Van Diepeningen, A.D.; Van Den Ende, A.H.G.G.; Li, R.Y.; Moussa, T.A.A.; Almaghrabi, O.A.; De Hoog, G.S. DNA barcoding of clinically relevant Cunninghamella species. Med. Mycol. 2015, 53, 99–106. [Google Scholar] [CrossRef] [PubMed]
- Tovar Pedraza, J.M.; Mora Aguilera, J.A.; Díaz, C.N.; Ortiz, D.T.; Villegas Monter, V.; Leyva Mir, S.G. Control of Lasiodiplodia theobromae, the causal agent of dieback of sapote mamey [Pouteria sapota (Jacq.) H.E. Moore and Stearn] grafts in México. Rev. Fitotec. Mex. 2013, 36, 233–238. [Google Scholar] [CrossRef]
- Dixit, R.; Singh, R.B.; Singh, H.B. Screening of antagonistic potential and plant growth promotion activities of Trichoderma spp. and fluorescent Pseudomonas spp. isolates against Sclerotinia sclerotiorum causing stem rot of French bean. Legum. Res. 2015, 38, 375–381. [Google Scholar] [CrossRef]
- Vinale, F.; Sivasithamparam, K.; Ghisalberti, E.L.; Marra, R.; Barbetti, M.J.; Li, H.; Woo, S.L.; Lorito, M. A novel role for Trichoderma secondary metabolites in the interactions with plants. Physiol. Mol. Plant Pathol. 2008, 72, 80–86. [Google Scholar] [CrossRef]
- Zhang, S.; Xu, B.; Zhang, J.; Gan, Y. Identification of the antifungal activity of Trichoderma longibrachiatum T6 and assessment of bioactive substances in controlling phytopathgens. Pestic. Biochem. Physiol. 2018, 147, 59–66. [Google Scholar] [CrossRef]
- Srinivasa, N.; Sriram, S.; Singh, C.; Shivashankar, K.S. Secondary Metabolites Approach to study the bio-efficacy of Trichoderma asperellum isolates in India. Int. J. Curr. Microbiol. Appl. Sci. 2017, 6, 1105–1123. [Google Scholar] [CrossRef]
- Sang, M.K.; Kim, K.D. The volatile-producing Flavobacterium johnsoniae strain GSE09 shows biocontrol activity against Phytophthora capsici in pepper. J. Appl. Microbiol. 2012, 113, 383–398. [Google Scholar] [CrossRef]
- Li, T.; Wang, H.; Xia, X.; Cao, S.; Yao, J.; Zhang, L. Inhibitory effects of components from root exudates of Welsh onion against root knot nematodes. PLoS ONE 2018, 13, e0201471. [Google Scholar] [CrossRef]
- Hussein, H.M.; Hameed, I.H.; Ibraheem, O.A. Antimicrobial activity and spectral chemical analysis of methanolic leaves extract of adiantum capillus-veneris using GC-MS and FT-IR spectroscopy. Int. J. Pharmacogn. Phytochem. Res. 2016, 8, 369–385. [Google Scholar]
- Shareef, H.K.; Muhammed, H.J.; Hussein, H.M.; Hameed, I.H. Antibacterial effect of ginger (Zingiber officinale) roscoe and bioactive chemical analysis using gas chromatography mass spectrum. Orient. J. Chem. 2016, 32, 817–837. [Google Scholar] [CrossRef]
- Go, W.Z.; H’ng, P.S.; Wong, M.Y.; Chin, K.L.; Ujang, S.; Noran, A.S. Evaluation of Trichoderma asperellum as a potential biocontrol agent against Rigidoporus microporus Hevea brasiliensis. Arch. Phytopathol. Plant Prot. 2019, 52, 639–666. [Google Scholar] [CrossRef]
- Pandey, S.; Shahid, M.; Srivastava, M.; Sharma, A.; Singh, A.; Kumar, V. Isolation, purification and characterization of glucanase enzyme from the antagonistic fungus Trichoderma. Int. J. Sci. Eng. Res. 2014, 5, 646–649. [Google Scholar]
- Rashid, S.; Charles, T.C.; Glick, B.R. Isolation and characterization of new plant growth-promoting bacterial endophytes. Appl. Soil Ecol. 2012, 61, 217–224. [Google Scholar] [CrossRef]
- Spaepen, S.; Vanderleyden, J. Auxin and Plant-Microbe Interactions. Cold Spring Harb. Perspect. Biol. 2011, 1, a001438. [Google Scholar] [CrossRef]
- Muniroh, M.S.; Nusaibah, S.A.; Vadamalai, G.; Siddique, Y. Proficiency of biocontrol agents as plant growth promoters and hydrolytic enzyme producers in Ganoderma boninense infected oil palm seedlings. Curr. Plant Biol. 2019, 20, 100116. [Google Scholar] [CrossRef]
- Brummel, D.A.; Hall, J.L. Rapid cellular responses to auxin and the regulation of growth. Plant. Cell Environ. 1987, 10, 523–543. [Google Scholar] [CrossRef]
- Ngamau, C.N.; Matiru, V.N.; Tani, A.; Muthuri, C.W. Potential use of endophytic bacteria as biofertilizer for sustainable banana (Musa spp.) production. Afr. J. Hortic. Sci. 2014, 8, 1–11. [Google Scholar]
- Ahmed, E.; Holmström, S.J.M. Siderophores in environmental research: Roles and applications. Microb. Biotechnol. 2014, 7, 196–208. [Google Scholar] [CrossRef]
- Kobayashi, T.; Nishizawa, N.K. Iron uptake, translocation, and regulation in higher plants. Annu. Rev. Plant Biol. 2012, 63, 131–152. [Google Scholar] [CrossRef]
- De Boer, M.; Bom, P.; Kindt, F.; Keurentjes, J.J.B.; Van Der Sluis, I.; Van Loon, L.C.; Bakker, P.A.H.M. Control of Fusarium wilt of radish by combining Pseudomonas putida strains that have different disease-suppressive mechanisms. Phytopathology 2003, 93, 626–632. [Google Scholar] [CrossRef]

| Treatment | Description |
|---|---|
| T1 | Tree without inoculation of R. microporus |
| T2 | Tree inoculated with R. microporus and without application of biocontrol suspension or chemical fungicide |
| T3 | Biocontrol application with 100 mL of 108 cfu/mL suspension of T. asperellum ST011 to the planting media once a week for a month before the tree is inoculated with an R. microporus wood block |
| T4 | Biocontrol application with 100 mL of 108 cfu/mL suspension of T. spirale HT009 to the planting media once a week for a month before the tree is inoculated with an R. microporus wood block |
| T5 | Biocontrol application with 100 mL of 108 cfu/mL suspension of T. asperellum ST011 + T. spirale HT009 to the planting media once a week for a month before the tree is inoculated with an R. microporus wood block |
| T6 | Chemical application with 100 mL Kentil propiconazole 250 EC in a diluted form of 1% to the planting media once a week for a month before the tree is inoculated with an R. microporus wood block |
| Scoring | Above-Ground Symptom | Below-Ground Symptom |
|---|---|---|
| 0 | Healthy with green leaves | Fungal infections not found |
| 1 | 1–25% of yellowing leaves | Fungal infections in the root are less than 1% |
| 2 | 26–50% of wilted leaves | 1–10% of fungal infections in the root |
| 3 | 51–75% defoliation | 11–50% of fungal infections in the root |
| 4 | 76–100% death of the plant | 51–90% of fungal infection in the root |
| 5 | - | Fungal infections in the root of more than 90% |
| Isolate ID | Fungal Identity | Genbank Accession Number | Genbank Accession Number (% Identity) |
|---|---|---|---|
| HT001 | Trichoderma koningiopsis | MH512944 | EU718083 (100%) |
| HT002 | Talaromyces sp. | MH512945 | KY643686 (99%) |
| HT003 | Purpureocillium lilacinum | MH512946 | KX641490 (99.83%) |
| HT004 | Fusarium oxysporum | MH512947 | MG020429 (100%) |
| HT005 | Talaromyces aculeatum | MH512948 | KM458839 (99.83%) |
| HT006 | Talaromyces aculeatum | MH512949 | KM458839 (99.83%) |
| HT007 | Cunninghamella bainieri | MH512950 | KF201293 (99.86%) |
| HT008 | Metarhizium anisopliae | MH512951 | KX806656 (99.82%) |
| HT009 | Trichoderma spirale | MH512952 | JF439515 (99.67%) |
| HT010 | Penicillium sp. | MH512953 | KM066554 (100%) |
| HT011 | Purpureocillium lilacinum | MH512954 | KC478538 (100%) |
| HT012 | Penicillium sp. | MH512955 | KM066554 (100%) |
| HT013 | Clonostachys sp. | MH512956 | KY419566 (99.42%) |
| HT014 | Scedosporium boydii | MH512957 | KP132695 (99.35%) |
| HT015 | Trichoderma koningiopsis | MH512958 | EU718083 (100%) |
| HT016 | Aspergillus nomius | MH512959 | AB828718 (100%) |
| HT017 | Penicillium sp. | MH512960 | HM469409 (100%) |
| HT018 | Byssochlamys spectabilis | MH512961 | KC311513 (99.51%) |
| ST001 | Gongronella butleri | MN103605 | KM246758 (97.95%) |
| ST003 | Penicillium sp. | MH512962 | KM066554 (99.49%) |
| ST004 | Trichoderma spirale | MH512963 | JF439515 (99.83%) |
| ST005 | Fusarium oxysporum | MH512964 | MG020429 (100%) |
| ST006 | Trichoderma spirale | MH512965 | HQ229947 (100%) |
| ST007 | Xepicula leucotricha | MH512966 | KU847251 (97.94%) |
| ST008 | Penicillium sp. | MH512967 | KY425719 (100%) |
| ST009 | Trichosporiella sp. | MH512968 | DQ069049 (96.43%) |
| ST010 | Lasiodiplodia theobromae | MH512969 | KR260793 (100%) |
| ST011 | Trichoderma asperellum | MH512970 | MG657259 (100%) |
| ST012 | Arcopilus cupreus | MH512971 | MF599416 (97.61%) |
| ST013 | Trichoderma reesei | MH512972 | MH047196 (99.37%) |
| ST014 | Trichoderma koningiopsis | MH512973 | EU718083 (100%) |
| ST015 | Wiesneriomyces laurinus | MH512974 | KP057801 (86.12%) |
| ST016 | Penicillium singorense | MH512975 | LT558940 (100%) |
| ST017 | Byssochlamys spectabilis | MH512976 | KC254066 (100%) |
| ST018 | Clonostachys sp. | MH512977 | KX343160 (98.25%) |
| No. | Isolate ID | Fungal Identity | Radial Growth (mm) * | PIRG (%) * | Bell’s Ranking Scale Categories |
|---|---|---|---|---|---|
| 1 | HT001 | Trichoderma koningiopsis | 6.63 ± 1.10 bcd | 76.94 ± 3.84 cd | R1 |
| 2 | HT002 | Talaromyces sp. | 19.37 ± 1.06 jklm | 32.60 ± 3.67 ijkl | R4 |
| 3 | HT003 | Purpureocillium lilacinum | 15.94 ± 0.60 hij | 44.55 ± 2.08 ghi | R5 |
| 4 | HT004 | Fusarium oxysporum | 16.00 ± 1.15 hij | 44.35 ± 4.00 ghi | R4 |
| 5 | HT005 | Talaromyces aculeatum | 23.13 ± 0.70 mno | 19.52 ± 2.45 lmn | R3 |
| 6 | HT006 | Talaromyces aculeatum | 21.70 ± 2.25 lmn | 24.51 ± 7.83 klm | R4 |
| 7 | HT007 | Cunninghamella bainieri | 1.96 ± 0.29 a | 93.18 ± 1.02 a | R1 |
| 8 | HT008 | Metarhizium anisopliae | 25.19 ± 1.40 no | 12.36 ± 4.88 mn | R3 |
| 9 | HT009 | Trichoderma spirale | 5.88 ± 1.47 ab | 79.55 ± 5.12 bc | R2 |
| 10 | HT010 | Penicillium sp. | 19.03 ± 1.92 jkl | 33.78 ± 6.69 ijk | R3 |
| 11 | HT011 | Purpureocillium lilacinum | 16.82 ± 0.94 ijk | 41.48 ± 3.29 hij | R3 |
| 12 | HT012 | Penicillium sp. | 16.17 ± 1.92 hijk | 43.75 ± 6.68 ghi | R3 |
| 13 | HT013 | Clonostachys sp. | 30.23 ± 1.79 qr | nil | R4 |
| 14 | HT014 | Scedosporium boydii | 33.48 ± 1.62 qr | nil | R5 |
| 15 | HT015 | Trichoderma koningiopsis | 11.87 ± 0.77 efg | 58.72 ± 2.67 ef | R2 |
| 16 | HT016 | Aspergillus nomius | 8.67 ± 1.65 bcdef | 69.83 ± 5.72 cde | R1 |
| 17 | HT017 | Penicillium sp. | 12.68 ± 2.23 fgh | 55.90 ± 7.77 fg | R2 |
| 18 | HT018 | Byssochlamys spectabilis | 13.74 ± 1.75 ghi | 52.18 ± 6.10 fgh | R2 |
| 19 | ST001 | Gongronella butleri | 26.11 ± 0.75 op | 9.15 ± 2.60 n | R3 |
| 20 | ST003 | Penicillium sp. | 9.92 ± 1.52 cdefg | 65.49 ± 5.27 def | R3 |
| 21 | ST004 | Trichoderma spirale | 12.28 ± 1.64 efgh | 57.27 ± 5.69 efg | R2 |
| 22 | ST005 | Fusarium oxysporum | 13.13 ± 0.74 ghi | 54.33 ± 2.58 fgh | R4 |
| 23 | ST006 | Trichoderma spirale | 12.29 ± 1.50 efgh | 57.25 ± 5.23 efg | R2 |
| 24 | ST007 | Xepicula leucotricha | 29.87 ± 1.34 pqr | nil | R5 |
| 25 | ST008 | Penicillium sp. | 20.09 ± 1.28 klm | 30.11 ± 4.46 jkl | R4 |
| 26 | ST009 | Trichosporiella sp. | 33.80 ± 1.98 r | nil | R5 |
| 27 | ST010 | Lasiodiplodia theobromae | 5.41 ± 1.78 ab | 81.19 ± 6.20 abc | R1 |
| 28 | ST011 | Trichoderma asperellum | 2.01 ± 1.63 a | 93.02 ± 5.68 ab | R1 |
| 29 | ST012 | Arcopilus cupreus | 19.12 ± 0.91 jklm | 33.47 ± 3.15 ijk | R5 |
| 30 | ST013 | Trichoderma reesei | 10.59 ± 0.70 defg | 63.14 ± 2.43 n | R2 |
| 31 | ST014 | Trichoderma koningiopsis | 6.53 ± 1.53 bc | 77.28 ± 5.33 cd | R1 |
| 32 | ST015 | Wiesneriomyces laurinus | 29.46 ± 1.38 pq | nil | R5 |
| 33 | ST016 | Penicillium singorense | 21.98 ± 1.93 lmn | 23.52 ± 6.72 klm | R3 |
| 34 | ST017 | Byssochlamys spectabilis | 8.52 ± 1.75 bcde | 70.35 ± 6.10 cde | R1 |
| 35 | ST018 | Clonostachys sp. | 31.41 ± 0.65 qr | nil | R5 |
| 36 | - | Control | 28.74 ± 1.49 | - | - |
| Isolate (ID) | Concentration of Culture Filtrate (%) | Radial Growth (mm) * | PIRG (%) * |
|---|---|---|---|
| T. koningiopsis (HT001) | 75 | 50.90 ± 1.21 d | 10.20 ± 2.14 d |
| 50 | 60.01 ± 1.24 e | nil | |
| 25 | 64.01 ± 1.66 fg | nil | |
| T. spirale (HT009) | 75 | 17.01 ± 1.49 b | 70.00 ± 2.63 b |
| 50 | 28.51 ± 2.08 c | 49.71 ± 3.66 c | |
| 25 | 51.98 ± 0.95 d | 8.30 ± 1.68 d | |
| T. asperellum (ST011) | 75 | 12.02 ± 1.74 a | 78.80 ± 3.08 a |
| 50 | 12.81 ± 0.63 a | 77.41 ± 1.10 a | |
| 25 | 19.54 ± 0.99 b | 65.54 ± 1.75 b | |
| T. reesei (ST013) | 75 | 53.34 ± 1.89 d | 5.90 ± 3.32 d |
| 50 | 63.62 ± 0.97 f | nil | |
| 25 | 67.04 ± 0.57 g | nil | |
| Control | - | 56.69 ± 2.31 | - |
| Isolate (ID) | Radial Growth (mm) * | PIRG (%) * |
|---|---|---|
| T. koningiopsis (HT001) | 45.61 ± 1.08 c | 33.42 ± 1.93 b |
| T. spirale (HT009) | 42.63 ± 0.59 b | 37.77 ± 1.05 b |
| T. asperellum (ST011) | 30.30 ± 1.15 a | 55.77 ± 2.06 a |
| T. reesei (ST013) | 50.17 ± 0.81 d | 26.76 ± 1.44 c |
| Control | 68.51 ± 0.31 | - |
| Isolate (ID) | Retention Time | Probability | Compound Name | Molecular Formula | Area % | Compound Class |
|---|---|---|---|---|---|---|
| T. koningiopsis (HT001) | 16.10 | 75.15 | Benzeneacetic acid,4-hydroxy- | C8H8O3 | 1.24 | Acid |
| 19.92 | 95.73 | Benzenepropanoic acid,3,5-bis(1,1-dimethylethyl)-4-hydroxy-,methyl ester | C18H28O3 | 13.25 | Ester | |
| 27.56 | 76.20 | 13-Docosenamide,(Z)- | C22H43NO | 24.30 | Amide | |
| 27.98 | 66.20 | Dodecanoic acid,1,2,3-propanetriyl ester | C39H74O6 | 2.51 | Acid | |
| T. spirale (HT009) | 19.92 | 91.88 | Benzenepropanoic acid,3,5-bis(1,1-dimethylethyl)-4-hydroxy-,methyl ester | C18H28O3 | 9.95 | Ester |
| 20.20 | 61.42 | 3,5-di-tert-Butyl-4-hydroxyphenylpropionic acid | C17H26O3 | 3.65 | Acid | |
| 27.52 | 79.42 | 13-Docosenamide,(Z)- | C22H43NO | 32.32 | Amide | |
| 38.57 | 59.62 | (5á)Pregnane-3,20á-diol, 14à,18à-[4-methyl-3-oxo-(1-oxa-4-azabutane-1,4-diyl)]-,diacetate | C28H43NO6 | 1.38 | Ester | |
| T. asperellum (ST011) | 13.94 | 68.67 | 2-(4-Methoxyphenyl) ethanol | C9H12O2 | 5.69 | Alcohol |
| 14.66 | 69.16 | Benzeneethanol,4-hydroxy- | C8H10O2 | 18.42 | Alcohol | |
| 15.73 | 51.90 | 2,4-Di-tert-butylphenol | C14H22O | 2.07 | Phenol | |
| 16.14 | 71.40 | Benzeneacetic acid,4-hydroxy- | C8H8O3 | 1.53 | Acid | |
| 27.52 | 81.40 | 13-Docosenamide,(Z)- | C22H43NO | 11.98 | Amide | |
| 34.53 | 57.36 | Dodecanoic acid,1,2,3-propanetriyl ester | C39H74O6 | 8.59 | Acid | |
| 36.20 | 50.14 | 1-Dodecanoyl-3-myristoyl glycerol | C29H56O5 | 5.68 | Acid | |
| 36.49 | 54.14 | 1-Dodecanoyl-3-myristoyl glycerol | C29H56O5 | 3.07 | Acid | |
| T. reesei (ST013) | 12.56 | 59.24 | 4-Ketopimelic | C7H10O5 | 1.36 | Acid |
| 14.62 | 70.29 | Benzeneethanol,4-hydroxy- | C8H10O2 | 2.08 | Alcohol | |
| 15.73 | 50.67 | 2,4-Di-tert-butylphenol | C14H22O | 3.25 | Phenol | |
| 18.13 | 62.84 | 11,13-Dihydroxy-tetradec-5-ynoic acid, methyl ester | C15H26O4 | 2.53 | Ester | |
| 19.92 | 96.59 | Benzenepropanoic acid, 3,5-bis(1,1-dimethylethyl)-4-hydroxy-,methyl ester | C18H28O3 | 17.11 | Ester | |
| 27.57 | 83.99 | 13-Docosenamide, (Z)- | C22H43NO | 36.05 | Amide |
| Isolate (ID) | Chitinase | Cellulase | β-1,3 Glucanase |
|---|---|---|---|
| T. koningiopsis (HT001) | 0.02 ± 0.00 b | 0.11 ± 0.01 c | 0.03 ± 0.00 b |
| T. spirale (HT009) | 0.02 ± 0.00 b | 0.18 ± 0.01 b | nil |
| T. asperellum (ST011) | 0.04 ± 0.00 a | 0.26 ± 0.03 a | 0.06 ± 0.00 a |
| T. reesei (ST013) | 0.02 ± 0.00 b | 0.04 ± 0.01 d | 0.02 ± 0.00 c |
| Isolate (ID) | IAA Production (µg/mL) * |
|---|---|
| T. koningiopsis (HT001) | nil |
| T. spirale (HT009) | nil |
| T. asperellum (ST011) | 1.68 ± 0.10 |
| T. reesei (ST013) | 0.83 ± 0.05 |
| Activity | Isolate (ID) * | ||||
|---|---|---|---|---|---|
| T. koningiopsis (HT001) | T. spirale (HT009) | T. asperellum (ST011) | T. reesei (ST013) | ||
| Antibiosis | Non-volatile metabolite | 2 | 3 | 4 | 2 |
| Volatile metabolite | 3 | 3 | 4 | 1 | |
| Hydrolytic enzyme | Chitinase | 3 | 3 | 4 | 3 |
| Cellulase | 2 | 3 | 4 | 1 | |
| β-1,3 glucanase | 3 | 0 | 4 | 2 | |
| Competition | Phosphate solubilization | 0 | 4 | 4 | 2 |
| IAA production | 0 | 0 | 4 | 3 | |
| Siderophore production | 1 | 4 | 2 | 3 | |
| Total score | 14 | 20 | 30 | 17 | |
| Treatment | DSI (%) | Average DSI (%) * | Efficacy (%) | |
|---|---|---|---|---|
| Above-Ground (Foliar Discoloration) | Below-Ground (Root Rotting) | |||
| T2 | 52.08 | 85.00 | 68.54 ± 23.28 | - |
| T3 | 21.88 | 35.00 | 28.44 ± 9.28 | 58.51 |
| T4 | 35.42 | 50.00 | 42.71 ± 10.31 | 37.69 |
| T5 | 20.83 | 35.00 | 27.92 ± 10.02 | 59.27 |
| T6 | 27.08 | 40.00 | 33.54 ± 9.13 | 51.06 |
| Treatment | Mortality Rate per Month (%) | Survival Rate at 6 MAI (%) * | |||||
|---|---|---|---|---|---|---|---|
| 1 | 2 | 3 | 4 | 5 | 6 | ||
| T2 | 0.00 | 12.50 | 20.83 | 16.67 | 8.33 | 8.33 | 33.33 ± 7.30 |
| T3 | 0.00 | 4.17 | 8.33 | 4.17 | 8.33 | 8.33 | 66.67 ± 3.40 |
| T4 | 0.00 | 8.33 | 12.50 | 8.33 | 12.50 | 8.33 | 50.00 ± 4.56 |
| T5 | 0.00 | 4.17 | 4.17 | 8.33 | 8.33 | 8.33 | 66.67 ± 3.48 |
| T6 | 0.00 | 4.17 | 8.33 | 8.33 | 12.50 | 8.33 | 58.33 ± 3.96 |
Disclaimer/Publisher’s Note: The statements, opinions and data contained in all publications are solely those of the individual author(s) and contributor(s) and not of MDPI and/or the editor(s). MDPI and/or the editor(s) disclaim responsibility for any injury to people or property resulting from any ideas, methods, instructions or products referred to in the content. |
© 2023 by the authors. Licensee MDPI, Basel, Switzerland. This article is an open access article distributed under the terms and conditions of the Creative Commons Attribution (CC BY) license (https://creativecommons.org/licenses/by/4.0/).
Share and Cite
Go, W.Z.; Chin, K.L.; H’ng, P.S.; Wong, M.Y.; Lee, C.L.; Khoo, P.S. Exploring the Biocontrol Efficacy of Trichoderma spp. against Rigidoporus microporus, the Causal Agent of White Root Rot Disease in Rubber Trees (Hevea brasiliensis). Plants 2023, 12, 1066. https://doi.org/10.3390/plants12051066
Go WZ, Chin KL, H’ng PS, Wong MY, Lee CL, Khoo PS. Exploring the Biocontrol Efficacy of Trichoderma spp. against Rigidoporus microporus, the Causal Agent of White Root Rot Disease in Rubber Trees (Hevea brasiliensis). Plants. 2023; 12(5):1066. https://doi.org/10.3390/plants12051066
Chicago/Turabian StyleGo, Wen Ze, Kit Ling Chin, Paik San H’ng, Mui Yun Wong, Chuan Li Lee, and Pui San Khoo. 2023. "Exploring the Biocontrol Efficacy of Trichoderma spp. against Rigidoporus microporus, the Causal Agent of White Root Rot Disease in Rubber Trees (Hevea brasiliensis)" Plants 12, no. 5: 1066. https://doi.org/10.3390/plants12051066
APA StyleGo, W. Z., Chin, K. L., H’ng, P. S., Wong, M. Y., Lee, C. L., & Khoo, P. S. (2023). Exploring the Biocontrol Efficacy of Trichoderma spp. against Rigidoporus microporus, the Causal Agent of White Root Rot Disease in Rubber Trees (Hevea brasiliensis). Plants, 12(5), 1066. https://doi.org/10.3390/plants12051066

